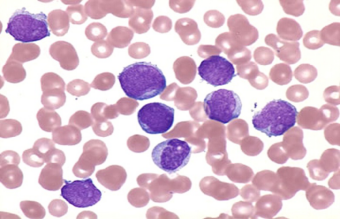

-
1 内容
-
2 作业
急性白血病
(Acute leukemia)
定义
急性白血病是由于某些致病因子作用与骨髓,引起某一系统造血细胞过度增生,进入血流并侵犯各组织器官,正常骨髓造血受到抑制,引起一系列临床表现的恶性增生性疾病,儿童期最常见的恶性肿瘤。
发热、贫血、出血、感染、组织侵犯
分类
◇ 急性淋巴细胞白血病(ALL)70%
◇ 急性非淋巴细胞白血病(AML)30%
◇ 其他:低增生性、浆细胞性白血病等

流行病学
◇ 年发病率2/10万-5/10万
◇ 我国3/10万-4/10万
◇ 2-7岁居多
◇ 90%为AL
病因
△ 病毒因素
△ 化学因素
△ 放射因素
△ 遗传因素
分类和分型

细胞形态学(FAB)
△ ALL-L1:小细胞为主
△ ALL-L2:大小不一、大细胞为主
△ ALL-L3:大小一致、大细胞为主

免疫学分型
◇ T-ALL: CD1,CD3,CD5,CD7,CD8, TdT阳性
◇ B-ALL: HLA-DR+, CD19+, CD10+, Cym, SmIg
◇ 髓系标志My+-ALL: CD13,CD33,CD14
细胞遗传学
◇ 染色体数目异常:低二倍体、高二倍体
◇ 染色体结构异常:易位、倒置
分子生物学
◇ 免疫球蛋白重链IgH基因重排
◇ T细胞受体基因TCR重排
◇ ALL相关融合基因
费城染色体 t(9;22)(q34;q11)
◇ 预后极差
◇ 耐药
√ 抗凋亡
√ 增生
√ 表达多重耐药跨膜转运蛋白
◇ 早期干细胞疾病
急性非淋巴细胞细胞白血病
◇ FAB分型:M0-M7
◇ 免疫学分型:CD33,CD13,CD14,CD15,MPO,CD41,CD68
◇ 细胞遗传学:t(8;21)t(15;17)等
临床表现和实验室检查

鉴别诊断
◇ 再生障碍性贫血
◇ 传染性单核细胞增生症
◇ 类白血病反应等
预后因素
◇ 初诊时年龄 & 白细胞数
√ 20% 病例> 50,000/μL--- 预后差
√ <1 year and > 10 years--- 预后差
√ <12 months ---预后最差.
◇ 性别: 女孩 vs 男孩
◇ E种族:
√ ---非洲后裔- 预后差
√ ---西班牙裔 –预后差?

◇ 细胞遗传学因素:
√ 高二倍体>50 染色体-预后好;
√ 低二倍体<45 染色体,假二倍体—预后差
√ t(9;22); , t(4;11), t(1 ;19) –预后差
√ t(12;21)---预后好, 16 to 18% of B-ALL 病例
◇ DNA 指数:>1.16
◇ 免疫分型:
√ T cell ALL---比B-ALL预后更差
√ Mature B-ALL-方案不同
√ My+-ALL: 有争议
◇ FAB : L3—预后欠佳; L1—预后好
t(9;22) ALL化疗效果差

◇ 早期反应:
√ ---Day 8 外周血 or Day 29 骨髓反应
√ ---MRD (微小残存病变) on day8 and 29

治疗原则-化疗综合治疗
◇ 早期诊断早期治疗
◇ 分类分型选取化疗方案
◇ 早期强烈、分阶段化疗
◇ 长期治疗、多药交替、全程治疗
◇ CNS、髓外AL治疗
◇ 支持治疗、防治并发症
治疗原则-一般治疗
◇ 防治感染
◇ 输血
◇ 集落刺激因子
◇ 高尿酸血症等并发症防治
◇ 营养护理等
治疗原则-化疗
◇ 诱导缓解期: VDLP
◇ 巩固治疗期: CAM
◇ 髓外白血病预防:HD MTX
◇ 维持和加强治疗:MM VP
◇ 髓外白血病治疗
◇ CNS白血病:鞘注IT、放疗
◇ TL白血病:切除、放疗
治疗原则-造血干细胞移植
◇ <10%患儿
◇ 骨髓移植
◇ 外周血干细胞移植
◇ 脐血移植
◇ 半相合骨髓移植
ALL治疗显著进步的原因
◇ 有效地抗白血病联合药物化疗
◇ 中枢神经系统(CNS)预防治疗
◇ 更细致的风险分层治疗
◇ 支持治疗的进步:抗感染药、血制品、营养
◇ 支持等
◇ 临床试验的进步
Advances in Treatment for Childhood COG SR-ALL
5-Year Event-Free Survival Rate

Outcomes from UKALL(UK)

Outcomes from St.Jude(USA)

急性非淋巴细胞白血病(AML)进展
AML预后因素
◇ 临床特征:年龄>10岁和<1岁—预后不良
√ 高白细胞---预后不良
√ APL早期使用ATRA---预后好
◇ 细胞遗传学和分子生物学特征:70-80%
√ 预后不良—t(1;22);t(9;22);t(6;9);-5,del(5q);-7
√ 预后良好—t(8;21);t(15;17);inv(16)
◇ 治疗反应
√ 第一疗程结束骨髓幼稚细胞>15%,未达CR
√ MRD检测阳性
AML化疗药物进展
◇ 细胞毒药物:核苷类、蒽环类、拓扑异构酶抑制剂、HHT等多药联合
◇ 诱导分化药物:ATRA、三氧化二砷治疗APL
◇ 靶向治疗:靶向免疫治疗、激酶、信号分子抑制剂、蛋白酶抑制剂等
√ CD33单抗---吉妥珠单抗—复发难治AML
◇ 化疗方案优化:药物联合、强度时间加大等
AML化疗造血干细胞移植进展
◇ 异基因造血干细胞移植
◇ 诱导后重要的巩固疗法
◇ 高危患儿优势明显
◇ 中高危患儿CR1进行移植
◇ 低危患儿CR2进行移植

儿童白血病中的其他靶向治疗与新药应用
◇ 急淋
√ FLT3/Ras 途径
* Sorafenib索拉非尼
√ JAK2
* Ruxolitinib - INCB018424
◇ 急非淋
√ FLT3/Ras 途径
* Sorafenib索拉非尼
√ 基因表达调节 -染色质靶向
* Decitabine地西他滨
要点
◇ 1、熟悉儿童白血病发病情况、种类及预后
◇ 2、了解儿童急性淋巴细胞白血病的治疗原则
◇ 3、了解儿童白血病的诊治进展

